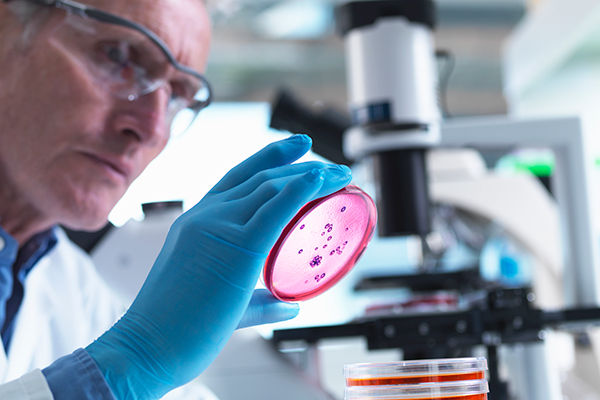
img

Bizimlə Tanış Olun !
V.Y.Axundov adına Elmi-Tədqiqat Tibbi Profilaktika İnstitutu 1922-ci ildə Azərbaycanda ilk elmi-tədqiqat institutu olaraq yaradılmış və 100 ildən artıqdır ki, fəaliyyətinə davam etməkdədir. İkinci dünya müharibəsi illərində SSRİ-ni peyvəndlə təmin edən yeganə institut olmuş və uzun illər infeksion xəstəliklərlə mübarizədə mühüm işlər görmüşdür. İnstitut Respublikada bakterial, virus, göbələk və parazitar mənşəli yoluxucu xəstəliklərin elmi əsaslandırılmış diaqnostika, müalicə və profilaktika üsullarının işlənilib hazırlanması və tətbiq edilməsini həyata keçirən elmi-metodik mərkəzdir.
İnstitut elmi və klinik hissədən ibarətdir. Elmi hissədə müxtəlif etiologiyalı yoluxucu xəstəliklərin diaqnostika və müalicə üsullarının elmi araşdırmalarla təkmilləşdirilməsi, eləcə də bu infeksiyaların profilaktikası və yayılmasının qarşısının alınması üçün eksepidemik tədbirlərin hazırlanması və həyata keçirilməsi əsas fəaliyyət istiqamətlərimizdəndir. Əsas məqsədlərimiz infeksion xəstəliklərin düzgün idarə olunması və fərdiləşdirilmiş terapiyaların hazırlanmasıdır.
Hədəfimiz sağlamlığınızı qoruyaraq, həyat keyfiyyətinizi yaxşılaşdırmaq və sizlərə yüksək keyfiyyətli xidmət göstərərək sağlamlığınız üçün ilk və ən doğru seçim olmaqla regionun ilk səhiyyə şəbəkəsi halına gəlməkdir.
Prof. Dr. Adil M. Allahverdiyev
Direktor
Xidmət Sahələrimiz
Şöbələr

Mikrobiologiya Şöbəsi
Müxtəlif materiallarda xəstəlik törədicilərinin (bakteriya, göbələk və virusların) indikasiyası, əldə edilməsi və identifikasiyası, elmi tədqiqatların istiqamətindən asılı olaraq onların müvafiq xüsusiyyətlərinin tədqiqi...
Daha ətraflı
Parazitar və Tropik Xəstəliklər Şöbəsi
Parazitar, o cümlədən tropik xəstəliklərin törədicilərinin aşkar edilməsi və identifikasiyası, elmi tədqiqatların istiqamətindən asılı olaraq onların müvafiq xüsusiyyətlərinin tədqiqi...
Daha ətraflı
İmmunologiya Şöbəsi
Şöbənin fəaliyyəti müasir immunoloji metodlardan istifadə etməklə immun mexanizmlərin pozulması nəticəsində yaranan patoloji proseslərin tədqiqi, diaqnostik və müalicəvi immun zərdabların və immunoqlobulinlərin hazırlanması...
Daha ətraflı
Epidemiologiya Şöbəsi
Epidemiologiya şöbəsinin elmi fəaliyyətinə Azərbaycan Respublikasında əhali populyasiyasında geniş yayılmış, reginol patologiya sayılan, endemik ocaqlı yoluxucu xəstəliklərin tədqiqi...
Daha ətraflı
Gigiyena Şöbəsi
Şöbənin elmi fəaliyyətinə ətraf mühitin (torpağın, suyun və havanın) gigiyenik qiymətləndirilməsi, onların çirkləndirilmə mənbələrinin aşkar edilməsi və sağlamlaşdırılması...
Daha ətraflı
Gen Mühəndisliyi və Biotexnologiya Şöbəsi
Şöbənin fəaliyyətinin əsas istiqamətləri - vaksin preparatlarının tədqiqi, yeni vaksinlərin hazırlanması, onların effektivliyinin öyrənilməsi...
Daha ətraflı
Vivarium
Laborator heyvanların (ağ siçan, dovşan, dəniz donuzu və s.) və digər heyvanların (qoyun, at və s.) saxlanılması,heyvanların eksperimentlərə hazırlanması və istifadəsi...
Daha ətraflı
Biobank
İnstitutun laboratoriyalarında əldə edilmiş, eləcə də digər müəsisələrdən alınmış törədici mikroorqanizmlərin (bakteriya, virus, göbələk və parazitlərin) təmiz kulturalarının standartlaşdırılması...
Daha ətraflıƏn Yeni
Xəbərlər və Tədbirlər
Təbriz Tibb Elmləri Universitetinin nümayəndəsi ilə görüş keçirilib.
Xəzər Universitetinin dəvəti ilə Azərbaycana gələn İran İslam Respublikasının Təbriz Tibb Elmləri Universitetinin əczaçılıq...
Davamını OxuTürkiyənin Ege və Akdeniz Universitetlərinin beynəlxalq səviyyədə tanınmış alimləri ilə görüş keçirilib.
I Beynəlxalq Parazitologiya Konfransı çərçivəsində Azərbaycanda səfərdə olan Türkiyə Parazitalogiya Dərnəyinin rəhbəri...
Davamını OxuElmi-Tədqiqat Tibbi Profilaktika İnstitutunun təşkilatçılığı ilə Bakıda I Beynəlxalq Parazitologiya Konfransı keçirilib.
4 oktyabr 2025-ci il tarixlərində Azərbaycan Respublikası Səhiyyə Nazirliyi V.Y. Axundov adına Elmi-Tədqiqat Tibbi Profilaktika...
Davamını OxuI Beynəlxalq Parazitologiya Konfransının ilk günü elmi-praktiki seminar keçirildi.
Azərbaycan Respublikası Səhiyyə Nazirliyi, İcbari Tibbi Sığorta üzrə Dövlət Agentliyi və TƏBİB-in dəstəyi ilə...
Davamını OxuƏrdəbil Tibb Elmləri Universitetinin nümayəndəsi ilə görüş keçirilib.
V.Y. Axundov adına Elmi-Tədqiqat Tibbi Profilaktika İnstitutunda İran İslam Respublikasının Ərdəbil Tibb Elmləri Universitetinin...
Davamını OxuSəhiyyə Nazirliyinin İnstitut direktoru dünyanın ən nüfuzlu alimləri siyahısına yenidən daxil edilib.
Azərbaycan Səhiyyə Nazirliyi V.Y. Axundov adına Elmi Tədqiqat Tibbi Profilaktika İnstitutunun direktoru, professor Adil M. Allahverdiyev, bu...
Davamını OxuAnım Günündə şəhidlərimizi dərin hörmətlə yad edirik.
Bu gün Səhiyyə Nazirliyi V.Y.Axundov adına Elmi-Tədqiqat Tibbi Profilaktika İnstitutunda 27 sentyabr – “Anım Günü” çərçivəsində...
Davamını OxuHÖRMƏTLİ HƏKİMLƏR!
Sizi böyük məmnuniyyətlə 3-4 oktyabr 2025-ci il tarixlərində keçiriləcək, I Beynəlxalq Parazitologiya Konfransına dəvət edirik!
Davamını OxuSəhiyyə Nazirliyi V.Y.Axundov adına Elmi-Tədqiqat Tibbi Profilaktika İnstitutunda Zəfər Gününə həsr olunan tədbir keçirilib.
Tədbirdə giriş sözü ilə çıxış edən institutun direktoru professor Adil Allahverdiyev Azərbaycan xalqının döyüş və hərb tarixinə...
Davamını OxuProfessor Adil M.Allahverdiyev Dünyanın Ən Nüfuzlu Alimləri Siyahısına daxil edilmişdir.
Azərbaycan Respublikası Səhiyyə Nazirliyi V.Y. Axundov adına Elmi Tədqiqat Tibbi Profilaktika İnstitutunun direktoru...
Davamını OxuNaxçıvan Muxtar Respublikasının Səhiyyə Nazirliyi tərəfindən “İqlim Dəyişikliyinin Sağlamlığa Təsiri” adlı konfrans keçirilib.
Səhiyyə Nazirliyi V.Y.Axundov adına Elmi-Tədqiqat Tibbi Profilaktika İnstitutunun direktoru, professor Adil Allahverdiyev...
Davamını Oxu





















